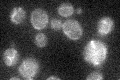
YLR289W
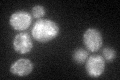
YLR289W
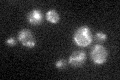
YLR289W

View description
Mitochondrial matrix GTPase that associates with mitochondrial ribosomes; important for translation under temperature and nutrient stress; may have a role in translational fidelity; similar to bacterial LepA elongation factor
Localization:
Intensity:
Fold change:
Significance:
-
C’ GFP library in SD
mitochondria21.63 -
N' NOP1pr-GFP in SD

N/A0 -
N' TEF2pr-mCherry in SD

N/A0 -
N' NATIVEpr-GFP in SD

N/A0 -
N' TEF2pr-VC and Cyto-VN in SD

N/A0 -
C’ GFP library in SD+DTT
mitochondria22.641.04No -
C’ GFP library in SD+H2O2
mitochondria23.571.08No -
C’ GFP library in Starvation Media

mitochondria22.111.02No -
C’ GFP library on the background of Pup2-DaMP

mitochondria -
C’ GFP library on the background of CCT mutant

mitochondria23.82731.10137No
